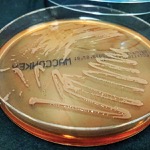

By Ethan Covey
Despite significant consequences to both patients and healthcare systems, non-ventilator hospital-acquired pneumonia (NV-HAP) is not well defined, understudied and poorly prevented, according to an article published in the Journal of Hospital Infection.

Better prevention of NV-HAP, the authors said, would improve patient care worldwide, while saving health systems considerable costs (J Hosp Infect 2024;151:201-212). Infectious disease professionals and health systems just need the data to support the proper interventions, according to Alana Livesey, MB BChir, of the National Institute for Health Research/Wellcome Trust Clinical Research Facility, University Hospitals Birmingham, in England.
“This publication highlights the lack of good-quality research studies in preventing NV-HAP, despite its significant impact on the morbidity and mortality of patients and financial implications on healthcare services worldwide,” said Dr. Livesay, the report’s lead author.
The narrative review offers an assessment of current prevention strategies as well as considerations regarding how best to address NV-HAP in the future.
Key to a better understanding of NV-HAP is developing a practical consensus definition of the condition. This will allow for routine monitoring of NV-HAP to fully ascertain its effect on patients and healthcare organizations, the authors stated.
Currently, the lack of a clear definition has resulted in clinical trials that lack specificity, often caused by enrollment of patients who have ventilator-acquired and/or community-acquired pneumonia. Additionally, existing trials often lacked recruitment and focused on a narrow range of patient groups.
Multiple prevention strategies exist for NV-HAP, including oral hygiene, management of aspiration risk, vaccination and physiotherapy. Many of the interventions are low risk, affordable, and may be beneficial for patients. Yet they remain understudied, and effectiveness requires the education and engagement of those involved, the researchers said.
Beyond prevention, risk factors for NV-HAP are increasing, the authors noted. The publication organizes the risk factors into three categories:
- individual patient characteristics;
- healthcare environment and modifiable factors; and
- non-modifiable factors.
“There are clear modifiable risk factors that can be addressed and show promise in small trials that should form the basis of larger, well-designed, randomized trials going forward,” Dr. Livesey said.
A goal, she said, is to address how healthcare professionals can prevent NV-HAP across the entire inpatient population who are at risk, and which strategies will be most acceptable and practicable for patients and healthcare staff.
An ideal study of NV-HAP, the authors proposed, would include a large cohort of adult hospital patients, and would be structured as a cluster randomized trial comparing ward-based interventions with matched control wards.